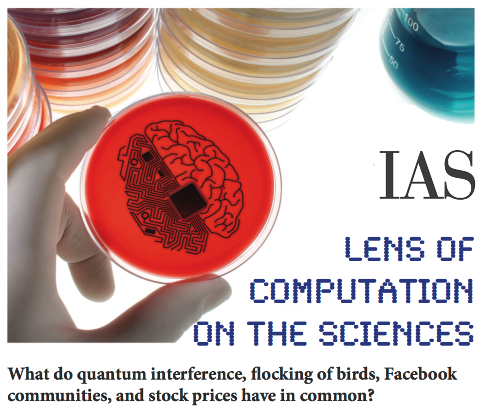

Lens of Computation on the Sciences
Many natural and social phenomena may be viewed as inherently computational; they evolve patterns of information that can be described algorithmically and studied through computational models and techniques. This workshop on the computational lens, organized by Avi Wigderson, Herbert H. Maass Professor in the School of Mathematics at the Institute for Advanced Study, highlights the state-of-art and future challenges of this interaction of computational theory with physics, social sciences, economics, and biology.